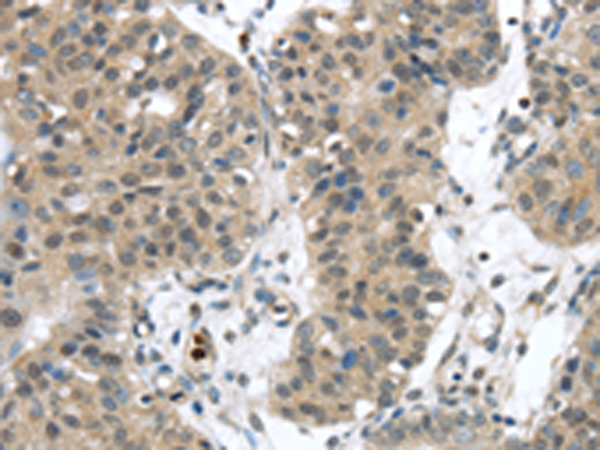

别名:SSP1; SUSP1应用:WB,IHC
反应种属:Human
规格:50μl/100μl
| Description |
|---|
| Ubiquitin-like molecules (UBLs), such as SUMO1 (UBL1; MIM 601912), are structurally related to ubiquitin (MIM 191339) and can be ligated to target proteins in a similar manner as ubiquitin. However, covalent attachment of UBLs does not result in degradation of the modified proteins. SUMO1 modification is implicated in the targeting of RANGAP1 (MIM 602362) to the nuclear pore complex, as well as in stabilization of I-kappa-B-alpha (NFKBIA; MIM 164008) from degradation by the 26S proteasome. |
| Specification | |
|---|---|
| Aliases | SSP1; SUSP1 |
| Swissprot | Q9GZR1 |
| WB Predicted band size | 126 kDa |
| Host/Isotype | Rabbit IgG |
| Storage | Store at 4°C short term. Aliquot and store at -20°C long term. Avoid freeze/thaw cycles. |
| Species Reactivity | Human |
| Immunogen | Synthetic peptide of human SENP6 |
| Formulation | pH7.4 PBS, 0.05% NaN3, 40% Glycerol |
| Application | |
|---|---|
| WB | 1/200-1/1000 |
| IHC | 1/25-1/100 |
| ELISA | 1/1000-1/2000 |
 |
Gel: 6%SDS-PAGE, Lysate: 40 μg, Lane 1-2: Hela cells, K562 cells, Primary antibody: P05270(SENP6 Antibody) at dilution 1/450, Secondary antibody: Goat anti rabbit IgG at 1/8000 dilution, Exposure time: 5 minutes |
|
The image is immunohistochemistry of paraffin-embedded Human breast cancer tissue using P05270(SENP6 Antibody) at dilution 1/20. (Original magnification: ×200) |
本公司的所有产品仅用于科学研究或者工业应用等非医疗目的,不可用于人类或动物的临床诊断或治疗,非药用,非食用。
暂无评论
本公司的所有产品仅用于科学研究或者工业应用等非医疗目的,不可用于人类或动物的临床诊断或治疗,非药用,非食用。
 中文
中文 








发表回复